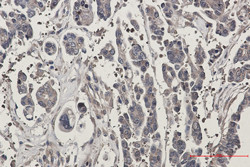
STK39 Antibody in Immunohistochemistry (Paraffin) (IHC (P))

Search
Abnova
STK39 Recombinant Rabbit Monoclonal Antibody
{{$productOrderCtrl.translations['antibody.pdp.commerceCard.promotion.promotions']}}
{{$productOrderCtrl.translations['antibody.pdp.commerceCard.promotion.viewpromo']}}
{{$productOrderCtrl.translations['antibody.pdp.commerceCard.promotion.promocode']}}: {{promo.promoCode}} {{promo.promoTitle}} {{promo.promoDescription}}. {{$productOrderCtrl.translations['antibody.pdp.commerceCard.promotion.learnmore']}}
产品信息
RAB01356
种属反应
宿主/亚型
Expression System
分类
类型
抗原
偶联物
形式
纯化类型
保存液
内含物
保存条件
运输条件
靶标信息
STK39 (STLK3) is involved in the cellular stress response pathway. STK39 is activated in response to hypotonic stress leading to phosphorylation of several cation-chloride-coupled co-transporters. STK39 activates the p38 MAP kinase pathway and its interaction with p38 decreases during cellular stress. STK39 acts as an intermediate in the response to cellular stress. STK39 is also an independent risk factor for hypertension in men and its intragenic SNPs can interact and function in the control of blood pressure.
仅用于科研。不用于诊断过程。未经明确授权不得转售。
篇参考文献 (0)
生物信息学
蛋白别名: DCHT; DKFZp686K05124; proline-alanine-rich STE20-related kinase; serine threonine kinase 39 (STE20/SPS1 homolog, yeast); serine-threonine kinase; serine/threonine kinase homolog; Serine/threonine-protein kinase 39; small intestine SPAK-like kinase; Ste-20-related kinase; Ste20-like protein kinase; STE20/SPS1 homolog; STE20/SPS1-related proline-alanine-rich protein kinase
基因别名: DCHT; PASK; SPAK; STK39
UniProt ID: (Human) Q9UEW8
Entrez Gene ID: (Human) 27347